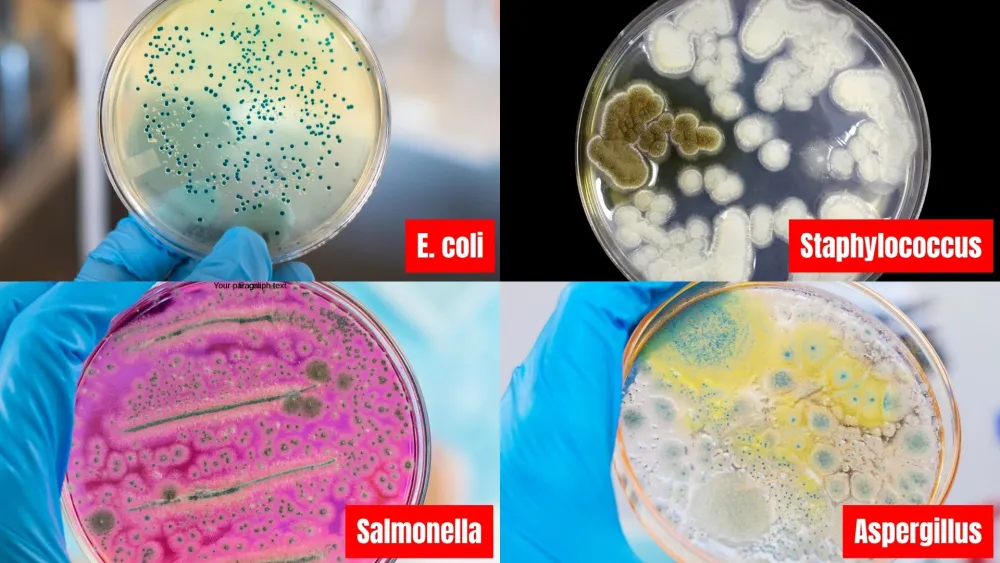
5

URGENT UPDATE: Limited Synoshi PRO units available at 70% OFF — Stock expected to sell out within 48 hours
Top Doctors Reveal: New Bacterial Epidemic Inside US Homes And Top 3 Cleaning Mistakes You're Making Right Now That Make It Worse
Written by Sarah Mitchell
Senior Medical Journalist
If you've noticed your family getting sick more often, persistent odors that won't go away, or unexplained allergies that seem to worsen at home, what you're about to discover could save your family's health.
Last month, I was granted exclusive access to a closed-door symposium at Johns Hopkins Medical Center, where leading infectious disease specialists gathered to discuss an alarming discovery that's being called "the hidden health crisis of modern homes."
What they revealed left me speechless — and terrified for my own family.
Dr. Marcus Chen, head of Environmental Microbiology at Johns Hopkins, presented data that made even seasoned doctors gasp:
"We're seeing bacterial colonies in American homes that are 300% more resistant than what we documented just five years ago. And the worst part? Traditional cleaning methods are actually making them stronger."
The room fell silent.
Then he dropped the bombshell:
"Your home is likely harboring between 7,000 and 10,000 different bacterial species right now. Most are invisible. Many are dangerous. And almost all of them are thriving because of three critical mistakes nearly every American makes when cleaning."
The 3 Deadly Cleaning Mistakes That Turn Your Home Into a Bacterial Breeding Ground
Mistake #1: Using the Same Cleaning Tools Everywhere
"This is bacterial cross-contamination on steroids," explained Dr. Chen, showing microscopic footage that made several attendees visibly uncomfortable.
When you use the same sponge, cloth, or brush to clean multiple surfaces, you're not cleaning — you're spreading a bacterial highway throughout your entire home.
The footage showed how bacteria from a toilet brush used just once spread to:
- Kitchen counters (where you prepare food)
- Door handles (touched 50+ times daily)
- Light switches (never properly cleaned)
- Children's toys (directly into their mouths)
Mistake #2: Believing "Clean-Looking" Means Actually Clean
Dr. Rebecca Torres, Chief of Pediatric Immunology at Boston Children's Hospital, presented the most disturbing findings:
"We tested 100 'spotless' homes. Every single one failed our bacterial safety standards. What looks clean to your eyes is often a thriving metropolis of dangerous microorganisms."
She showed before-and-after images using specialized detection equipment. Surfaces that appeared pristine lit up like Christmas trees under bacterial scanning — revealing colonies of:
- E. coli (causes severe digestive issues)
- Staphylococcus (leads to skin infections)
- Salmonella (food poisoning culprit)
- Aspergillus (triggers respiratory problems)
Mistake #3: Scrubbing With Inadequate Force and Speed
"Here's what nobody understands," said Dr. Chen, demonstrating with a standard cleaning brush. "Manual scrubbing achieves maybe 20-30 rotations per minute. Biofilms — the protective shields bacteria create — require at least 195 rotations per minute to break through."
This means every time you clean by hand, you're leaving behind 80% of the bacteria, protected by an invisible armor that gets stronger with each failed cleaning attempt.
The Stanford Discovery That Flipped The Script On Traditional Cleaning
Six months ago, researchers at Stanford's Clean Living Laboratory made a breakthrough that's revolutionizing how medical professionals think about home hygiene.
They discovered that combining three specific elements could eliminate 99.7% of household bacteria:
- Precise rotational force (195-235 RPM)
- Targeted pressure distribution (achieved through ergonomic angle adjustment)
- Visual contamination detection (using UV technology)
"It was like discovering antibiotics all over again," said Dr. Lisa Park, the study's lead researcher. "We finally had a way to win the war against household bacteria."
Japanese Solution That's Saving American Families
During the symposium's second day, we were introduced to Kenji Nakamura, Japan's leading hygiene technology expert, who had flown in specifically for this presentation.
"In Japan, we've eliminated these problems decades ago," he said matter-of-factly. "The solution isn't working harder — it's working smarter."
He then unveiled the Synoshi PRO — a device that looked like it belonged in a medical facility rather than a home.
Within weeks of its US launch, the Synoshi PRO exploded across mainstream media. Fox News, CBS, NBC, and ABC all featured segments showing shocked anchors discovering invisible contamination with the UV light. Synoshi PRO went viral on TikTok with over 47 million views, while YouTube cleaning experts called it "revolutionary."
"This represents 15 years of Japanese cleaning innovation, now enhanced with breakthrough American medical research," Nakamura explained.
The Synoshi PRO: Your Family's Defense Against the Bacterial Invasion
The Synoshi PRO isn't just another cleaning tool — it's a complete bacterial elimination system that addresses every mistake American families make:
Revolutionary Triple-Speed Motor Technology
- Low Speed (195 RPM): Safely cleans delicate surfaces without damage
- High Speed (235 RPM): Destroys stubborn biofilms and embedded bacteria
UV Detection System (The Game-Changer)
The built-in UV light reveals what your eyes can't see:
- Invisible urine splashes around toilets
- Bacterial colonies on "clean" surfaces
- Hidden mold in grout lines
- Contamination on toothbrush holders
"For the first time, you can actually SEE what you're fighting," Dr. Chen noted. "It's like giving someone night-vision goggles in a dark room."
Ergonomic Multi-Angle Design
- Three adjustable positions (0°, 36°, 72°)
- No more back pain from bending
- Reaches under toilets, behind fixtures, into corners
- Extendable handle reaches 6-foot ceilings without ladders
Quick-Swap Attachment System
Multiple specialized attachmesnts tackle every surface or cleaning task. On top of that, they come in pairs and are color coated, so you never mix up the bathroom attachment, with one you use in the kitchen.
- Firm bristles for tile and grout
- Soft bristles for delicate surfaces
- Corner brush for tight spaces
- Flat brush for large areas
Professional-Grade Features
2.5-hour battery life (3x longer than competitors)
Completely waterproof (safe for shower use)
414g lightweight design (won't tire your arms)
Cordless freedom (no outlet hunting)
Medical-grade materials (antimicrobial handle)
Real Families, Real Transformations
Jennifer K., Mother of Three, Austin TX
My youngest had constant respiratory issues. The pediatrician suggested environmental allergies. After using the Synoshi PRO with the UV light, I was HORRIFIED at what I found. Two weeks after proper cleaning, his symptoms disappeared. This device literally changed our lives."
Robert M., Grandfather, Phoenix AZ
"At 72, scrubbing on my hands and knees was becoming impossible. The Synoshi PRO's adjustable handle means I can clean everything while standing. My wife says our bathroom hasn't been this clean in years."
Maria S., Registered Nurse, Chicago IL
"I see infections daily at the hospital. Knowing what lurks in homes terrified me. The Synoshi PRO gives me peace of mind. The UV light showed contamination on surfaces I thought were sterile. Now I KNOW my home is actually clean."
The Hidden Costs of Bacterial Contamination
Consider what household bacteria really costs your family:
- Doctor visits for 'mysterious' illnesses: $200-500 per visit
- Allergy medications: $50-100 monthly
- Professional deep cleaning: $300-600 per session
- Lost work days to illness: $250-500 per day
- Emergency room visits for severe infections: $1,500-3,000
Total potential cost: $5,000-10,000 annually
The Synoshi PRO investment? Less than a single doctor's visit.
Why Medical Professionals Are Recommending Synoshi PRO
Dr. Torres concluded the symposium with this statement:
"If every American household had a Synoshi PRO, we'd see a 60% reduction in home-acquired infections. That's millions of prevented illnesses annually. This isn't just about cleanliness — it's about public health."
The American Cleaning Institute has even issued new guidelines recommending "mechanical cleaning assistance devices" for optimal home hygiene.
The Professional Cleaning Industry's Secret
Professional cleaning services have used similar technology for years. They charge $300-600 per deep clean because they know manual cleaning doesn't work.
The Synoshi PRO brings that same professional power to your home for a fraction of the cost.
What professionals know that you don't:
- Manual scrubbing spreads more bacteria than it removes
- Chemical cleaners without mechanical action are only 40% effective
- UV detection is essential for thorough cleaning
- Proper RPM speed breaks bacterial biofilms
Limited Time: 70% Warehouse Clearance
Due to overwhelming demand from the medical community's endorsements, Synoshi PRO inventory is critically low.
The manufacturer has authorized a 70% discount for the remaining units in their US warehouse — but only while supplies last.
What You Get With Your Order Today:
✅ Synoshi PRO Device
✅ 4 Specialized Brush Heads
✅ UV Detection System (built-in)
✅ 60-Day Money-Back Guarantee
✅ Free Priority Shipping
Is Synoshi PRO Right for Your Family?
Ask yourself:
- Does anyone in your home suffer from allergies or frequent illness?
- Do persistent odors return even after cleaning?
- Are you tired of scrubbing for hours with minimal results?
- Do you worry about what's really lurking on your "clean" surfaces?
- Is bending and scrubbing becoming physically difficult?
- Would you sleep better knowing your home is truly bacteria-free?
If you answered YES to any of these questions, the Synoshi PRO isn't just recommended — it's essential.
The Bottom Line: Your Family's Health Is Not Negotiable
Every day you wait is another day your family is exposed to dangerous bacteria multiplying in your home.
Every traditional cleaning session potentially makes the problem worse.
Every illness could have been prevented.
Dr. Chen's final words at the symposium haunt me: "In 10 years, we'll look back at manual cleaning the way we now view not washing hands before surgery — dangerous and primitive."
Don't let your family be part of the statistics.
Take Action Now — Before It's Too Late
🚨 WARNING: Due to recent media coverage, Synoshi PRO is selling out 10x faster than anticipated. Current inventory is expected to last less than 48 hours.
Your 60-Day Risk-Free Guarantee
Try the Synoshi PRO for 60 days. If you don't see a dramatic difference in your home's cleanliness — if the UV light doesn't reveal shocking contamination you never knew existed — return it for a full refund.
But we're confident that won't happen.
Because once you see what's really living in your home... and then watch the Synoshi PRO eliminate it... you'll never go back to primitive manual cleaning again.
Order Your Synoshi PRO Now
✅ 70% OFF Today Only
✅ Free Priority Shipping
✅ 60-Day Money-Back Guarantee
Inventory Status: ⚠️ CRITICAL - Less than 500 units remaining
Frequently Asked Questions
How is the Synoshi PRO different from other electric brushes?
The Synoshi PRO features medical-grade triple-speed technology, UV contamination detection, and ergonomic angle adjustment — features not found in generic alternatives.
Is it safe for all surfaces?
Yes. With three speed settings and multiple brush heads, the Synoshi PRO safely cleans everything from delicate glass to tough outdoor grime.
How long does the battery last?
A full charge provides 2.5 hours of continuous use — enough to deep clean your entire home multiple times.
Can I use my regular cleaning products?
Yes, though we recommend our eco-safe cleaning tablets for optimal results and to protect the device's longevity.
What if I'm not satisfied?
You're protected by our 60-day money-back guarantee. Simply return the device for a full refund, no questions asked.
How quickly will I receive my order?
Orders placed today ship within 24 hours via priority mail. Most customers receive their Synoshi PRO within 3-5 business days.
Is the UV light safe?
Absolutely. The UV light is designed for detection only and is completely safe for home use.
This is an advertisement and not a news article, blog post, or consumer protection update. Statements have not been evaluated by the FDA. This product is not intended to diagnose, treat, cure, or prevent any disease. Individual results may vary.
Top Doctors Approved: Eliminate 99.7% of Deadly Bacteria in Minutes
Jennifer K.
"The UV light revealed bacteria EVERYWHERE. My son's allergies disappeared after 2 weeks of proper cleaning with Synoshi PRO."
Stock Warning: ⚠️ Critical Stock Alert: Only 487 units remaining. Current page visitors: 1,249